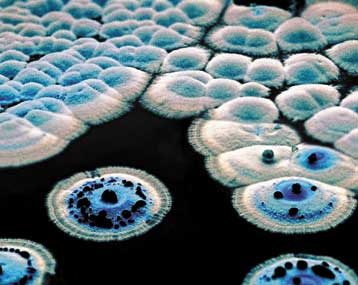
Ολοκληρώθηκε η καταγραφή του γονιδιώματος της στρεπτομυκίνης

Σε απολύσεις 8.000 άτομων θα προχωρήσει σύντομα, σύμφωνα με πληροφορίες, η ΙΒΜ
Η ΙΒΜ, ο κολοσσός της βιομηχανίας υπολογιστών, εκτιμάται ότι θα προχωρήσει σύντομα σε μαζικές απολύσεις σημαντικού αριθμού υπαλλήλων της σε σύνολο 318.000 ατόμων, όπως δημοσιεύεται στο φύλλο της Παρασκευής της εφημερίδας Wall Street Journal.

Αριθμός Πιστοποίησης Μ.Η.Τ.232442